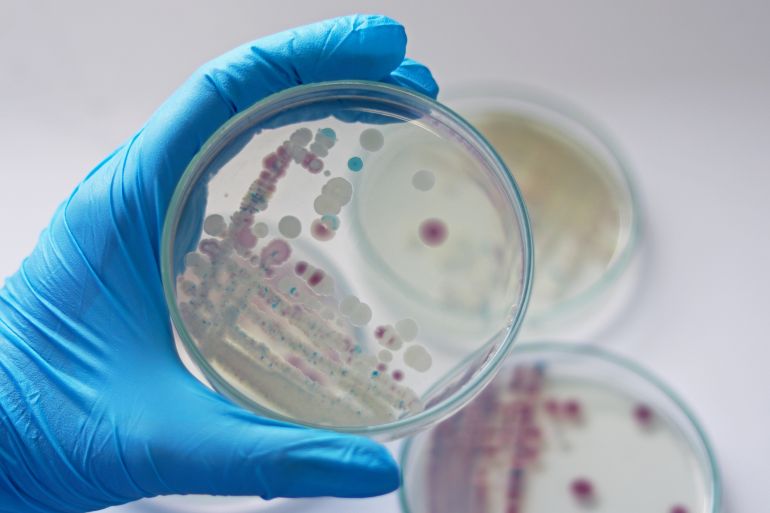

[ad_1]
إدانة مصر للاعتداءات العسكرية الإسرائيلية
أعربت مصر عن إدانتها لاستمرار الاعتداءات العسكرية الإسرائيلية في الضفة الغربية، والتي أسفرت عن استشهاد وإصابة العديد من الفلسطينيين خلال الأيام الأخيرة. كما نددت بالسياسة الإسرائيلية المعروفة بـ”الأرض المحروقة”، مؤكدة على أهمية احتواء التصعيد العسكري.
انتقاد استخدام القوة العسكرية المفرطة
في بيان صادر عن وزارة الخارجية والهجرة، استنكرت مصر الأحد محاولات التوسع الإسرائيلية في المواجهات على الأراضي الفلسطينية، بما يشمل الضفة الغربية والقدس الشرقية. واعتبرت استخدام القوة العسكرية بشكل مفرط، إضافة إلى عمليات القتل والتدمير وعمليات الاعتقال والتعذيب، انتهاكات خطيرة لا بد من محاسبة مرتكبيها.
دعوة دولية لحماية الفلسطينيين
شددت القاهرة على ضرورة أن تتقيد إسرائيل بالتزاماتها كقوة احتلال، وأن تحافظ على أمن السكان الفلسطينيين. كما حذرت من المخاطر الناجمة عن سياسة “الأرض المحروقة”، التي تهدف إلى تدمير آمال الفلسطينيين في إقامة دولتهم المستقلة. ودعت المجتمع الدولي ومجلس الأمن للتحرك بشكل حازم ضد هذه الممارسات غير الشرعية وحماية الشعب الفلسطيني.

تحذير من تصعيد النزاع
أكدت مصر على ضرورة احتواء التصعيد العسكري في الضفة الغربية، معتبرة أن مسؤولية توفير الأمن للسكان الفلسطينيين تقع على عاتق إسرائيل. جاء ذلك خلال لقاء وزير الخارجية المصري، بدر عبد العاطي، مع كبيرة منسقي الأمم المتحدة للشؤون الإنسانية، سيغريد كاغ، في القاهرة.
التعاون مع الأمم المتحدة في تقديم المساعدات
أشاد الوزير عبد العاطي بالتعاون بين الأمم المتحدة و”الهلال الأحمر المصري”، مشدداً على أهمية تسهيل إدخال المساعدات الإنسانية إلى قطاع غزة. كما أكد على ضرورة تسريع الإجراءات اللازمة لذلك بعيداً عن أي عراقيل من قبل إسرائيل.

جهود دولية لتخفيف معاناة الفلسطينيين
رحب المتحدث الرسمي لوزارة الخارجية، أحمد أبو زيد، بالمسؤولة الأممية، مشيراً إلى التزام مصر باستمرار دعم جهود إدخال المساعدات الإنسانية إلى الشعب الفلسطيني. كما أعرب عبد العاطي عن قلق مصر من تكرار الأحداث المأساوية في غزة داخل الضفة الغربية.
استعرضت سيغريد كاغ خلال اللقاء الجهود التي بُذلت لتسهيل إدخال وتوزيع المساعدات في غزة، وأكدت على التعاون المستمر مع مصر لجمع المزيد من المساعدات الإنسانية حال تحسن الظروف الأمنية.
رابط المصدر
[ad_2]